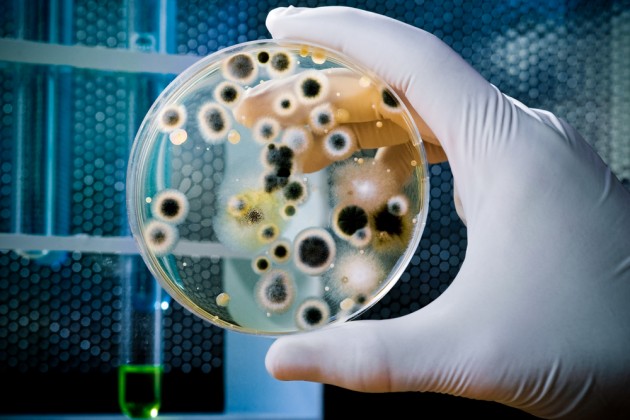

Serene and sustainable: Primark’s new cotton homewear collection
With the rise of eco-consciousness, it's no surprise that certain popular brands are catching up to the importance of sustainable materials.
Primark's homewear ranges are always ones to watch, but their latest collection featuring 100 percent sustainable cotton has us racing down to the store.
A fresh set of bedding can be the pinnacle of bedroom relaxation, and their latest range is perfect for your bed-time oasis of calm.
Primark have taken inspiration from refined Nordic interiors, creating a selection of soft Scandinavian greys and crisp white linens for the ideal minimalistic home.
The range serves as the perfect base for colour blocking with your favourite colours. The fresh, spa-worthy sustainable towels add to the theme, and are only €9 each.

Image: Primark Home
Primark's reusable cup is just €6, for those of you who no longer want to waste cardboard takeaway coffee/tea cups.
The rise in popularity of Keep Cups are most likely contributing to brands like Primark focusing on reusable homewear features.

Their gorgeous striped duvet cover single set comes in at the affordable price of €11, the double is just €16 while the king is €20.
Utilising sustainable materials such as cotton rather than microplastics of synthetic materials (polyester) can do wonders for the environment.
Supporting brands like Primark in their quest to reduce harmful materials is hugely important, and the affordability can't be denied. Why not head down and check out the latest range before it sells out?
Feature image: Instagram/@primark.home